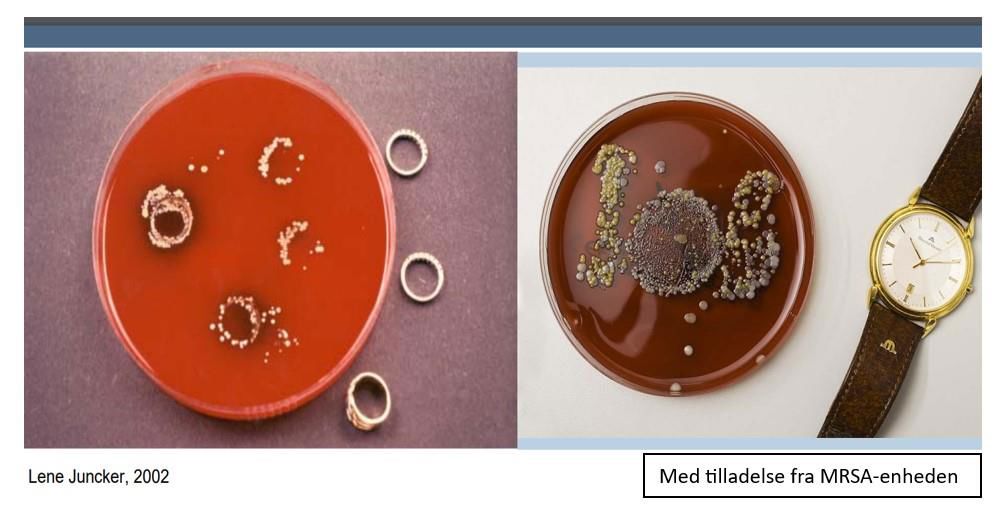

Til dig der passer på borgere på institution, centre og lign.
Denne side med undersider er møntet på plejecentre, visse bosteder og sundhedsfaglige behandlingssteder - hvor der er skærpede krav til hygiejne.
Sikker håndhygiejne
Derfor er ringe og ure "no-go" ved sundhedsfaglige opgaver - hvad der gror under ure og håndsmykker ...

Video: Effektiv hånddesinfektion tager tid - brug lige 30 sekunder (ingen lyd)
Video: Når håndvask skal gøre en forskel
Pas på dine hænder - forebyg håndeksem
Tørre hænder og hænder med eksem, sår og rifter udgør indgangsport for bakterier. Pas derfor godt på dine hænder, så huden plejes og holdes hel.
Sæbe irriterer huden
- Brug ikke sæbe på tørre hænder – skyl hænderne først.
- Skyl hænderne grundigt for sæberester.
- Prioriter hånddesinfektion frem for håndvask, hvor det er anbefale.
Fugt irriterer huden
- Dup hænderne helt tørre efter håndvask.
- Brug kun håndsprit på helt tørre hænder. Sprit på våde hænder øger hudbarrierens gennemtrængelighed.
Få fuld effekt af glycerolen
Gnid håndspritten ind i huden til huden er tør. Glycerol plejer din hud. Hvis spritten "lufttørrer", får du ikke gnedet glycerolen ind i dybden – hvor den skal virke!
Handsker - godt og skidt
Brug handsker, når det er anbefalet – men ikke mere end det! Brug af handsker øger fugten på hænderne.
Hel hud = sund hud
Brug en fed håndcreme – på tidspunkter, hvor den får lov at virke:
- I pauser
- Efter endt arbejdsdag
- Når du skal sove.
Hygiejnetrappen - Socialområdet
Værktøj til at bestemme det relevante smitteforebyggende hygiejne-niveau ift. opgaven



